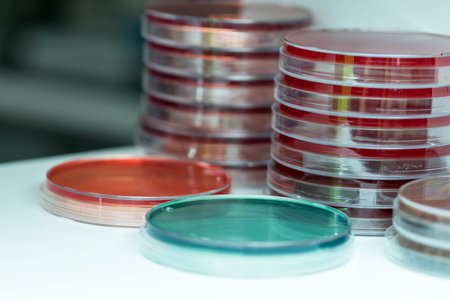
Xylose lysine deoxycholate agar (XLD agar) and thiosulphate-citrate-bile salts-sucrose(TCBS) agar.の写真素材

写真素材 - Xylose lysine deoxycholate agar (XLD agar) and thiosulphate-citrate-bile salts-sucrose (TCBS) agar.
作品情報
Xylose lysine deoxycholate agar (XLD agar) and thiosulphate-citrate-bile salts-sucrose (TCBS) agar.
- ID:99218436
- 作品種別:写真
- 作者名:Sirirat Makprasert
キーワード
- Media
- Salmonela
- Salmonella
- Shigella
- Vibrio
- agar
- air
- aureus
- background
- bacteria
- bacterial
- bacterium
- biology
- biotechnology
- black
- blood
- cell
- colony
- color
- culture
- danger
- diagnostic
- dish
- fecal
- food
- growth
- health
- healthcare
- hygiene
- isojation
- isolate
- isolated
- lab
- laboratory
- medical
- medicine
- medium
- micro
- microbe
- microbiology
- pathogen
- pathogens
- petri
- plate
- plates
- red
- research
- risk
- safety
- science
- scientific
- selective
- shigella
- streak
- test
- treat
- urine
- yellow
類似作品
Petri dish with...
Nutritional yea...
Petri dishes wi...
Petri dish with...
Hydrolyzed Coll...
Petri dish with...
closeup photo o...
Hydrolyzed coll...
Candida spp. - ...
Yeast in petri ...
Backgrounds of ...
Bacterial cultu...
Shimmer bubbles...
Backgrounds of ...
Black bacterial...
A vibrant yello...
Melioidosis sic...
Abstracted text...
Collagen protei...
Backgrounds of ...
Petri dish with...
Petri dish with...
Top view of the...
Yeast in petri ...
growth of bacte...
Backgrounds of ...
Mixed of bacter...
Backgrounds of ...
Backgrounds of ...
Organic gelatin...
Semolina wheat ...
Texture of natu...
Backgrounds of ...
Art from Colony...
Background with...
Yeast in petri ...
Backgrounds of ...
Colonies of mic...
Listeria, bacte...
Backgrounds of ...
Backgrounds of ...
mask pack formu...
Hands holding a...
Petri dish with...
coloring pigmen...
White cosmetic ...
Backgrounds of ...
Two Petri dishe...
The germs in th...